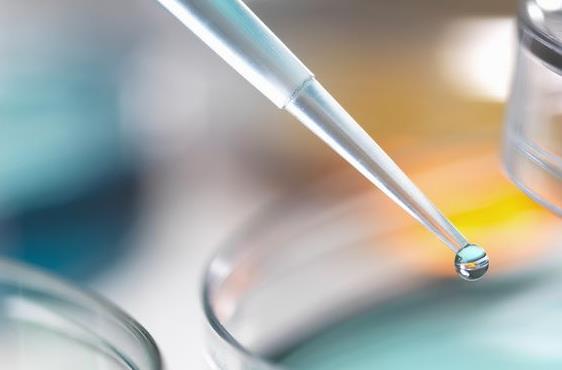
高雄激素血症可否在广东妇幼做三代试管取得成功？

高雄激素血症可否在广东妇幼做三代试管取得成功?
时间:2023-04-27 分类: 试管婴儿 查看: 32
问题描述:
患有高雄激素血症过高。该疾病会导致卵巢功能障碍,使得自然受孕的成功率大幅降低。由于夫妻二人长期没有怀孕的迹象,他们想尝试三代试管婴儿技术来实现生育愿望。精选回答:
高雄激素血症过高是一种常见的内分泌失调疾病,其主要表现为男性化特征和月经不调等。该疾病会导致卵巢功能障碍,从而影响女性的生育能力。对于像您这样的患者来说,三代试管婴儿技术是一种可行的选择。
三代试管婴儿技术是一种现代辅助生殖技术,它可以帮助那些因为各种原因无法自然怀孕的夫妇实现生育愿望。在这个过程中,精子和卵子被取出并在体外进行授精。然后,在胚胎发育到足月之前,将胚胎移植回母体。这样可以提高生育成功率,同时也为夫妇带来更多的选择。
对于患有高雄激素血症过高的女性来说,三代试管婴儿技术可能是一种更好的选择。但是在进行该项技术之前,医生需要对患者进行全面的身体检查,并评估其是否适合进行该项技术。此外由于三代试管婴儿技术涉及到多个步骤和复杂的操作过程,因此需要在专业医生的指导下进行。
重点提示:
高雄激素血症过高会影响女性的生育能力,使得自然受孕的成功率大幅降低。对于这样的患者来说,三代试管婴儿技术可能是一种更好的选择。但在选择是否采用该项技术时应当综合考虑其优缺点,并注意减少风险。此外在选择医院和医生时也应当多加考虑,选择专业、有经验的医疗机构和医师进行治疗。
试管婴儿技术 |
广东试管婴儿 |
展开全文